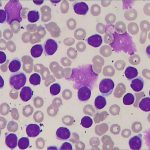
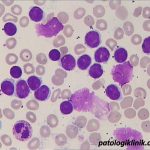
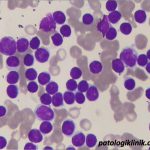
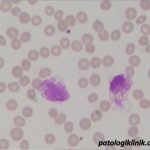
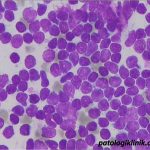

Chronic Lymphocytic Leukemia (CLL)
Kriteria diagnostik (morfologi) CLL:
- Limfositosis >5.000/uL
- Ciri limfosit: matur, ukuran kecil, sitoplasma sedikit, inti padat, nukleoli tidak terlihat
- bisa ditemukan smudge cells
- bisa ditemukan prolimfosit
Kriteria klinis (modified Rai staging system):
- Low risk: limfositosis
- Intermediate risk: limfositosis, limfadenopati, splenomegali, dan/atau hepatomegali
- High risk: Hb<11 g/dL atau trombosit <100.000/uL